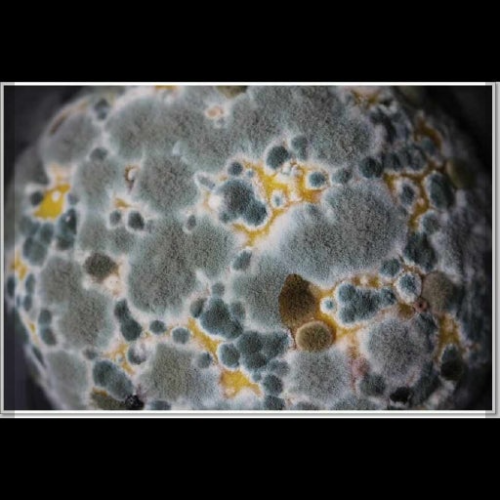

곰팡이 발생 조건과 예방책: 온도·습도의 조합이 만드는 환경
곰팡이는 왜 생기고, 어떻게 예방할 수 있을까?

곰팡이 발생의 과학적 조건
곰팡이는 공기 중에 존재하는 미세한 포자가 적절한 환경을 만나 성장할 때 발생한다. 그 핵심 요인은 바로 온도와 습도다. 일반적으로 곰팡이는 20~30℃의 온도에서 가장 활발하게 번식하며, 상대습도 60% 이상이 유지되면 빠르게 성장한다. 특히 환기가 부족하고 결로가 자주 생기는 공간은 곰팡이 발생의 최적 환경이 된다. 기상학적으로 습도가 높을수록 공기 중 수분이 포화 상태에 가까워져 표면에 응축이 발생하고, 이 수분이 곰팡이 성장의 발판이 되는 것이다.

온도와 습도의 조합
곰팡이는 단순히 습도가 높다고 해서 생기는 것이 아니라, 온도와 습도의 조합이 맞아떨어질 때 본격적으로 번식한다. 예를 들어 겨울철 실내 온도가 25℃로 유지되면서 외부와의 온도 차로 결로가 발생하면, 상대습도가 70% 이상에 도달하여 벽지나 창틀에 곰팡이가 쉽게 생긴다. 여름철 장마 기간에는 기온이 높고 습도 역시 80% 이상 지속되어 곰팡이 발생이 극심해진다. 즉, “따뜻하고 습한 환경”이 곰팡이의 가장 이상적인 번식 조건이라 할 수 있다.
곰팡이가 주는 피해
곰팡이는 단순히 보기 흉한 문제를 넘어, 건강과 생활 환경에 심각한 영향을 준다. 곰팡이 포자는 호흡기를 자극해 알레르기, 천식, 비염 등을 유발할 수 있으며, 일부 곰팡이는 독소를 생성해 장기적인 건강 문제를 일으킨다. 또한 건축 자재의 부식을 촉진하고, 가구나 의류의 손상을 가속화한다. 따라서 곰팡이 발생 조건을 정확히 이해하고, 이를 차단하는 것이 무엇보다 중요하다.

곰팡이 예방을 위한 생활 습관
- 환기 습관: 하루 2~3회 창문을 열어 공기를 순환시키면 습도 축적을 막을 수 있다.
- 제습기와 환풍기 활용: 습도가 60% 이상 올라갈 경우 제습기를 가동하거나 환풍기를 사용해 곰팡이 번식 환경을 차단한다.
- 온도 관리: 겨울철 실내 난방 시 과도한 온도 상승을 피하고, 표면 결로를 예방하기 위해 단열을 보강한다.
- 청소와 소독: 곰팡이가 잘 생기는 창틀, 욕실, 벽면은 주기적으로 소독제를 사용해 청결을 유지한다.
- 습기 원인 차단: 빨래를 실내에 장시간 두지 않고, 물기 제거를 철저히 한다.

맺음말: 곰팡이 없는 건강한 생활 환경
곰팡이는 온도와 습도의 균형이 깨질 때 자연스럽게 발생하는 현상이지만, 생활 속 관리와 습관으로 충분히 예방할 수 있다. 곰팡이 발생 조건을 이해하고 실내 환경을 조절하는 것은 단순한 청결 관리가 아니라, 건강을 지키는 과학적 실천이다. 작은 습관 하나가 곰팡이 없는 쾌적한 집을 만드는 첫걸음이 될 것이다.
'기상학' 카테고리의 다른 글
| "비 오는 날 음악 선택" (0) | 2025.08.20 |
|---|---|
| "와인 숙성과 기후" (0) | 2025.08.20 |
| "이슬 ·서리 ·안개" (0) | 2025.08.19 |
| "날씨와 여행·레저 산업" (0) | 2025.08.19 |
| "전기요금과 날씨" (0) | 2025.08.19 |